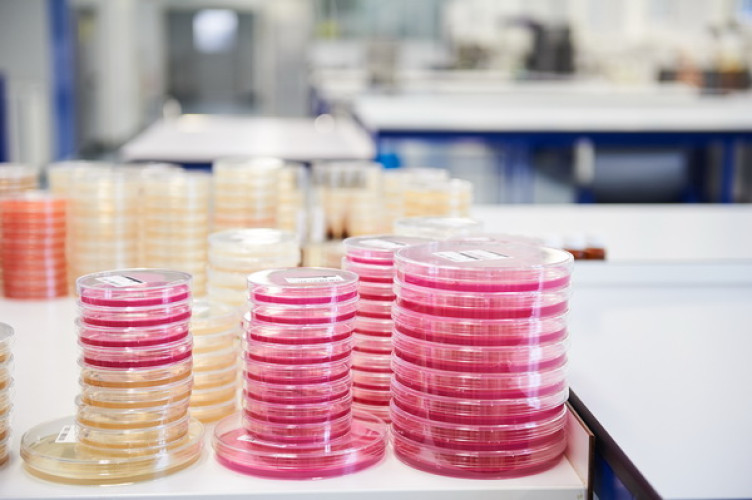

News
04.09.2020 - Mikrobiologie
Ursachen für Kontaminationen mit Listeria monocytogenes finden
Da es sich bei Listeria monocytogenes um ubiquitär auftretende Bakterien handelt, die in unserer Umwelt relativ häufig anzutreffen sind, ist es im Fall von Kontaminationen von Lebensmitteln häufig sehr schwierig rückwirkend die Ursache dafür sicher zu identifizieren.
Das BAV INSTITUT bietet eine Möglichkeit, dass mit modernster Labortechnik unterschiedliche Stämme von Listeria spp. bzw. Listeria monocytogenes miteinander verglichen werden können. So kann man z.B. Stämme aus Endprodukten mit Stämmen aus Rohstoffen oder Umgebungsuntersuchungen miteinander vergleichen und feststellen, ob es sich um die gleichen Stämme handelt. Diese Untersuchungen erfolgen mittels MALDI-TOF und werden mit einer speziellen Software ausgewertet. Die Ergebnisse liegen nach der Isolierung noch am gleichen Tag vor.
Damit können sichere Aussagen über Kontaminationsursachen sowie entsprechende Vorbeugungsmaßnahmen schnell eingeleitet werden.
Diese Möglichkeit zum Vergleich von Stämmen isolierter Mikroorganismen ist mittels der beim BAV INSTITUT eingeführten Methoden auch bei anderen Keimen wie z.B. Salmonellen, Bacillus cereus, Staphylococcus aureus… möglich.
Bei Fragen stehen wir Ihnen gerne zur Verfügung.
Kontakt:
Paul Andrei
Tel.: +49 781 96 94 715
E-Mail: paul.andrei@bav-institut.de
